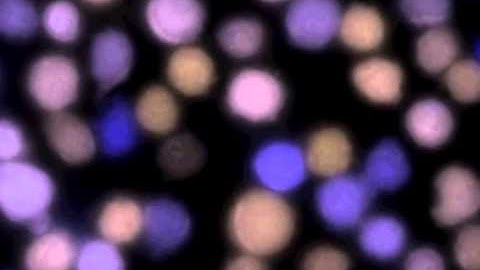
Imaging: lymphocytes

⬇ DOWNLOAD NOW
Kalau muncul iklan pop-up, tutup lalu klik tombol kembali
Download lagu Calcium Release Assay on ImageXpress Micro System secara gratis hanya untuk keperluan promosi. Dukung artis favorit kamu dengan membeli musik original di iTunes atau platform resmi lainnya.
 ImageXpress Micro System Workflow Demonstration
ImageXpress Micro System Workflow Demonstration
 T-Cell Activation Calcium Flux
T-Cell Activation Calcium Flux
Imaging: lymphocytes
Imaging: lymphocytes
 ImageXpress Micro Confocal Launch Video
ImageXpress Micro Confocal Launch Video
 High-Speed Calcium Imaging of Isolated Mouse Atrial Cardiomyocytes
High-Speed Calcium Imaging of Isolated Mouse Atrial Cardiomyocytes
 ImageXpress micro label free fluor hela DNA damage
ImageXpress micro label free fluor hela DNA damage
 Cell-based Calcium Assay: Medium To High Throughput Screening Using FlexStation 3 l Protocol Preview
Cell-based Calcium Assay: Medium To High Throughput Screening Using FlexStation 3 l Protocol Preview
 calcium-0001.flv
calcium-0001.flv